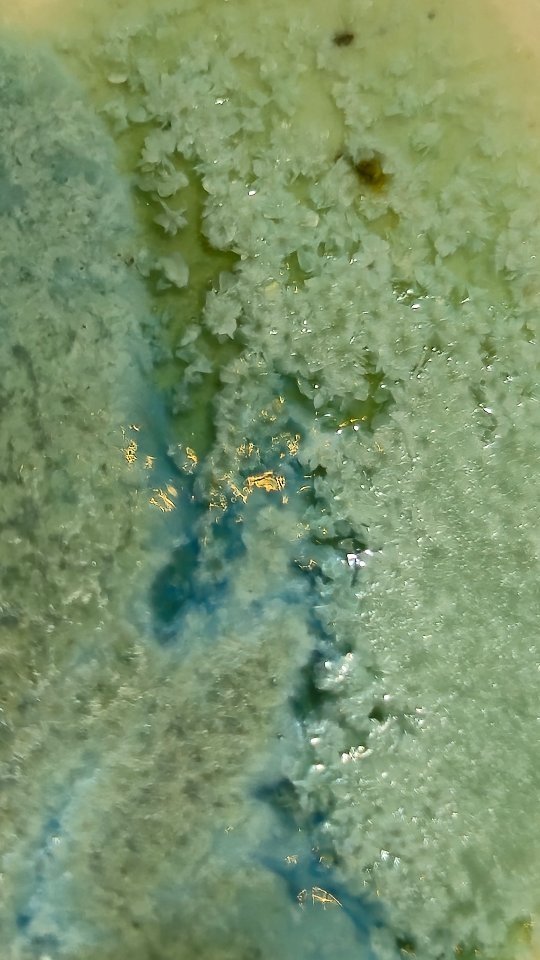

About Me
Artistic Purpose
My purpose as an artist is to create magical and welcoming worlds that help others discover and embrace their most authentic selves.
Hello! I’m Patricia, a multidisciplinary artist based in Tulum, Mexico.
My work flows between architecture, ceramics, and visual arts — a journey shaped by curiosity, nature, and hands-on creation.
I studied Architecture at the Universidad Nacional Autónoma de México (UNAM), which provided me with a solid foundation in design, composition, spatiality, geometry, and technical skills. Later, I pursued Ceramics at the School of Crafts at the National Institute of Fine Arts and Literature, reconnecting with materiality and craft. I have also deepened my knowledge at other respected institutions, including the Academy of San Carlos / Faculty of Arts and Design, CIDI, Anáhuac Mayab University, the University of the Environment, and Casa Lamm.
From 2017 to 2019, I collaborated at Tatiana Bilbao Estudio, a beautiful and creative architecture studio where collage, pencil, and paper were essential starting points for each project. There, I participated in social projects and expanded my expertise in bioconstruction techniques and museography.
At the end of the pandemic, feeling restless from confinement and the surrounding circumstances, I embarked on a new adventure in the Mexican Caribbean—surrounded by nature and near the waves.
Today, I run my ceramics studio at Holistika Tulum, a holistic center embraced by trees, birds, and beautiful natural light. There, I teach workshops and create my ceramic pieces.
I believe moving between different disciplines enriches my creative freedom. I love designing and being part of the entire process because I feel my intention and essence are embedded in every work.
Academic Background
-
Universidad Nacional Autónoma de México, 2012-2017.
-
Escuela de Artesanias, Inistituto Nacional de Bellas Artes, 2019-2022.
-
Academia de San Carlos, 2017.
-
Universidad Anahuac.
@Patty.Pottery
Contact Me
Interested in working together? Fill out some info and I will be in touch shortly. I can’t wait to hear from you!